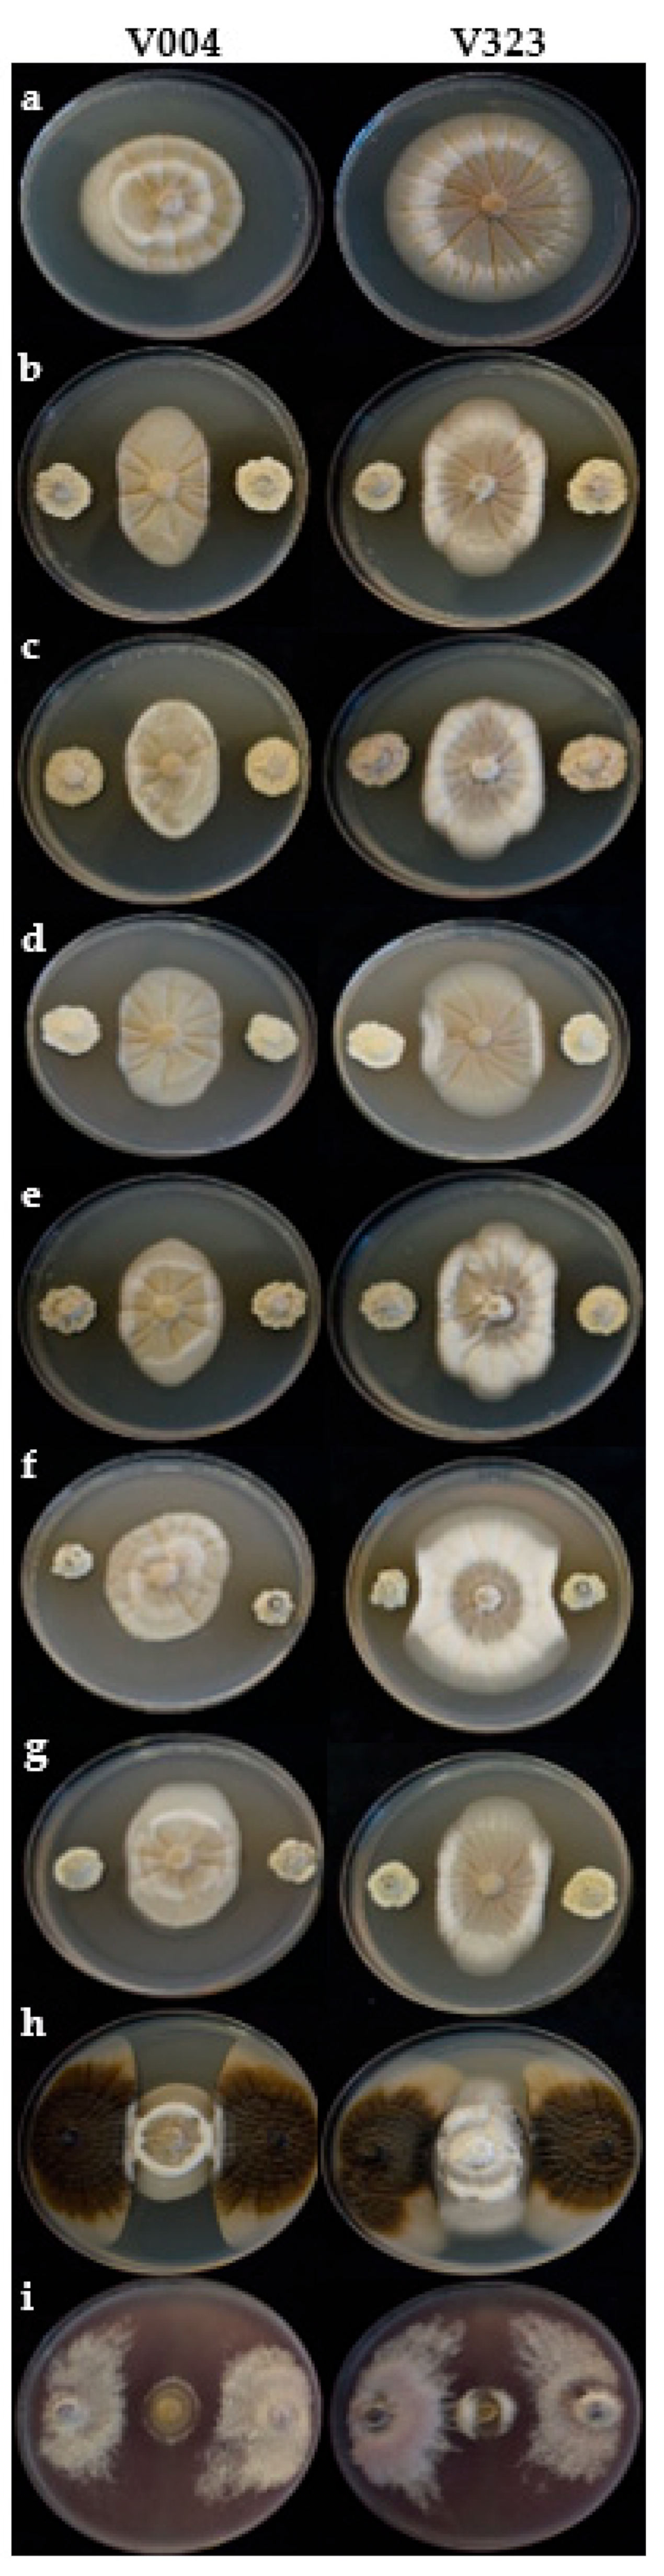
Jof 10 00138 g003

Streptomyces spp. Strains as Potential Biological Control Agents against Verticillium Wilt of Olive
Abstract
1. Introduction
2. Materials and Methods
2.1. Fungal Isolates and Culture Conditions
2.2. Biological Control Agents and Inoculum Preparation
2.3. Molecular Characterization of Streptomyces Strains
2.3.1. DNA Extraction, PCR Analysis, and Sequencing
2.3.2. Phylogenetic Analysis
2.4. Effect of Streptomyces spp. on Verticillium dahliae Viability
2.4.1. Effect on Mycelial Growth
2.4.2. Effect on Microsclerotia Viability
2.5. Effect of Streptomyces spp. on Disease Development in Olive Plants
2.5.1. Plant Material and Growth Conditions
2.5.2. Biological Control Agents
2.5.3. Verticillium dahliae Isolate and Inoculum Preparation
2.5.4. Biological Treatments and V. dahliae Inoculation
2.5.5. Disease Severity Assessment
2.6. Data Analysis
3. Results
3.1. Molecular Characterization of Streptomyces Strains
3.2. Effect of Streptomyces spp. on Verticillium dahliae Viability
3.2.1. Effect on Mycelial Growth
3.2.2. Effect on Microsclerotia Viability
3.3. Effect of Streptomyces spp. on Disease Development in Olive Plants
4. Discussion
5. Conclusions
Author Contributions
Funding
Institutional Review Board Statement
Informed Consent Statement
Data Availability Statement
Acknowledgments
Conflicts of Interest
References
- Montes-Osuna, N.; Mercado-Blanco, J. Verticillium wilt of olive and its control: What did we learn during the last decade? Plants 2020, 9, 735. [Google Scholar] [CrossRef] [PubMed]
- MAPA. 2022. Available online: https://www.mapa.gob.es/es/estadistica/temas/estadisticas-agrarias/agricultura/superficies-producciones-anuales-cultivos/ (accessed on 9 July 2023).
- López-Escudero, F.J.; Mercado-Blanco, J. Verticillium wilt of olive: A case study to implement an integrated strategy to control a soil-borne pathogen. Plant Soil 2011, 344, 1–50. [Google Scholar] [CrossRef]
- López-Moral, A.; Sánchez-Rodríguez, A.R.; Trapero, A.; Agustí-Brisach, C. Establishment of a method to collect root exudates from olive plants and its validation by determining the effect of root exudates against Verticillium dahliae. Plant Soil 2023, 483, 625–642. [Google Scholar] [CrossRef]
- López-Moral, A.; Agustí-Brisach, C.; Trapero, A. Plant biostimulants: New insights into the biological control of Verticillium wilt of olive. Front. Plant Sci. 2021, 12, 662178. [Google Scholar] [CrossRef] [PubMed]
- Varo, A.; Mulero-Aparicio, A.; Adem, M.; Roca, L.F.; Raya-Ortega, M.C.; López-Escudero, F.J.; Trapero, A. Screening water extracts and essential oils from Mediterranean plants against Verticillium dahliae in olive. Crop Prot. 2017, 92, 168–175. [Google Scholar] [CrossRef]
- Antón-Domínguez, B.I.; López-Moral, A.; Romero-Salguero, F.J.; Trapero, A.; Trapero, C.; Agustí-Brisach, C. Bioprotection of olive trees against Verticillium wilt by pomegranate and carob extracts. Plant Dis. 2023. [Google Scholar] [CrossRef] [PubMed]
- Varo, A.; Raya-Ortega, M.C.; Agustí-Brisach, C.; García-Ortiz-Civantos, C.; Fernández-Hernández, A.; Mulero-Aparicio, A.; Trapero, A. Evaluation of organic amendments from agro-industry waste for the control of Verticillium wilt of olive. Plant Pathol. 2018, 67, 860–870. [Google Scholar] [CrossRef]
- Mulero-Aparicio, A.; Trapero, A.; López-Escudero, F.J. A non-pathogenic strain of Fusarium oxysporum and grape marc compost control Verticillium wilt of olive. Phytopathol. Mediterr. 2020, 59, 159–167. [Google Scholar] [CrossRef]
- Gómez-Lama-Cabanás, C.; Ruano-Rosa, D.; Legarda, G.; Pizarro-Tobías, P.; Valverde-Corredor, A.; Triviño, J.C.; Roca, A.; Mercado-Blanco, J. Bacillales members from the olive rhizosphere are effective biological control agents against the defoliating pathotype of Verticillium dahliae. Agriculture 2018, 8, 90. [Google Scholar] [CrossRef]
- López-Moral, A.; Llorens, E.; Scalschi, L.; García-Agustín, P.; Trapero, A.; Agustí-Brisach, C. Resistance induction in olive tree (Olea europaea) against Verticillium wilt by two beneficial microorganisms and a copper phosphite fertilizer. Front. Plant Sci 2022, 13, 831794. [Google Scholar] [CrossRef]
- Azabou, M.C.; Gharbi, Y.; Medhioub, I.; Ennouri, K.; Barham, H.; Tounsi, S. The endophytic strain Bacillus velezensis OEE1: An efficient biocontrol agent against Verticillium wilt of olive and a potential plant growth promoting bacteria. Biol. Control 2020, 142, 104168. [Google Scholar]
- Castro, D.; Torres, M.; Sampedro, I.; Martínez-Checa, F.; Torres, B.; Béjar, V. Biological control of Verticillium wilt on olive trees by the salt-tolerant strain Bacillus velezensis XT1. Microorganisms 2020, 8, 1080. [Google Scholar] [CrossRef] [PubMed]
- Markakis, E.A.; Tjamos, S.E.; Antoniou, P.P.; Paplomatas, E.J.; Tjamos, E.C. Biological control of Verticillium wilt of olive by Paenibacillus alvei, strain K165. Biocontrol 2016, 61, 293–303. [Google Scholar] [CrossRef]
- Gómez-Lama-Cabanás, C.; Legarda, G.; Ruano-Rosa, D.; Pizarro-Tobías, P.; Valverde-Corredor, A.; Niqui, J.L.; Triviño, J.; Roca, A.; Mercado-Blanco, J. Indigenous Pseudomonas spp. strains from the Olive (Olea europaea L.) rhizosphere as effective biocontrol agents against Verticillium dahliae: From the host roots to the bacterial genomes. Front. Microbiol. 2018, 9, 277. [Google Scholar] [CrossRef] [PubMed]
- Mercado-Blanco, J.; Rodríguez-Jurado, D.; Hervás, A.; Jiménez-Díaz, R.M. Suppression of Verticillium wilt in olive planting stocks by root-associated fluorescent Pseudomonas spp. Biol. Control 2004, 30, 474–486. [Google Scholar] [CrossRef]
- Mansoori, M.; Heydari, A.; Hassanzadeh, N.; Rezaee, S.; Naraghi, L. Evaluation of Pseudomonas and Bacillus bacterial antagonists for biological control of cotton Verticillium wilt disease. J. Plant Prot. Res. 2013, 53, 154–157. [Google Scholar] [CrossRef]
- Montes-Osuna, N.; Gómez-Lama-Cabanás, C.; Valverde-Corredor, A.; Berendsen, R.; Prieto, P.; Mercado-Blanco, J. Assessing the involvement of selected phenotypes of Pseudomonas simiae PICF7 in olive root colonization and biological control of Verticillium dahliae. Plants 2021, 10, 412. [Google Scholar] [CrossRef]
- Varo, A.; Raya-Ortega, M.C.; Trapero, A. Selection and evaluation of microorganisms for biocontrol of Verticillium dahliae in olive. J. Appl. Microbiol. 2016, 121, 767–777. [Google Scholar] [CrossRef]
- Mulero-Aparicio, A.; Agustí-Brisach, C.; Varo, A.; López-Escudero, F.J.; Trapero, A. A non-pathogenic strain of Fusarium oxysporum as a potential biocontrol agent against Verticillium wilt of olive. Biol. Control 2019, 139, 104045. [Google Scholar] [CrossRef]
- Carrero-Carrón, I.; Trapero-Casas, J.L.; Olivares-García, C.; Monte, E.; Hermosa, R.; Jiménez-Díaz, R.M. Trichoderma asperellum is effective for biocontrol of Verticillium wilt in olive caused by the defoliating pathotype of Verticillium dahliae. Crop Prot. 2016, 88, 45–52. [Google Scholar] [CrossRef]
- Carrero-Carrón, I.; Rubio, M.B.; Niño-Sánchez, J.; Navas-Cortés, J.A.; Jiménez-Díaz, R.M.; Monte, E.; Hermosa, R. Interactions between Trichoderma harzianum and defoliating Verticillium dahliae in resistant and susceptible wild olive clones. Plant Pathol. 2018, 67, 1758–1767. [Google Scholar] [CrossRef]
- Morán-Diez, M.; Carrero-Carrón, I.; Rubio, M.; Jiménez-Díaz, R.M.; Monte, E.; Hermosa, R. Transcriptomic analysis of Trichoderma atroviride overgrowing plant-wilting Verticillium dahliae reveals the role of a new M14 metallocarboxypeptidase CPA1 in biocontrol. Front. Microbiol. 2019, 10, 1120. [Google Scholar] [CrossRef]
- Reghmit, A.; Benzina-Tihar, F.; López-Escudero, F.J.; Halouane-Sahir, F.; Oukali, Z.; Bensmail, S.; Ghozali, N. Trichoderma spp. isolates from the rhizosphere of healthy olive trees in northern Algeria and their biocontrol potentials against the olive wilt pathogen, Verticillium dahliae. Org. Agric. 2021, 11, 639–657. [Google Scholar] [CrossRef]
- Ruano-Rosa, D.; Prieto, P.; Rincón, A.M.; Gómez-Rodríguez, M.V.; Valderrama, R.; Barroso, J.B.; Mercado-Blanco, J. Fate of Trichoderma harzianum in the olive rhizosphere: Time course of the root colonization process and interaction with the fungal pathogen Verticillium dahliae. Biocontrol 2016, 61, 269–282. [Google Scholar] [CrossRef]
- Mulero-Aparicio, A.; Varo, A.; Agustí-Brisach, C.; López-Escudero, F.J.; Trapero, A. Biological control of Verticillium wilt of olive in the field. Crop Prot. 2020, 128, 104993. [Google Scholar] [CrossRef]
- Monteiro, P.; Borba, M.P.; Van Der Sand, S.T. Evaluation of the antifungal activity of Streptomyce ssp. on Bipolaris sorokiniana and the growth promotion of wheat plants. J. Agric. Sci. 2017, 9, 229. [Google Scholar]
- Olanrewaju, O.S.; Babalola, O.O. Streptomyces: Implications and interactions in plant growth promotion. Appl. Microbiol. Biotechnol. 2019, 103, 1179–1188. [Google Scholar] [CrossRef] [PubMed]
- Li, Y.; Guo, Q.; He, F.; Li, Y.; Xue, Q.; Lai, H. Biocontrol of root diseases and growth promotion of the tuberous plant Aconitum carmichaelii induced by Actinomycetes are related to shifts in the rhizosphere microbiota. Microb. Ecol. 2020, 79, 134–147. [Google Scholar] [CrossRef]
- Dalal, J.M.; Kulkarni, N.S. Antagonistic and plant growth promoting potentials of indigenous end ophytic actinomycetes of soybean (Glycine max (L) Merril). CIBTech J. Microbiol. 2014, 3, 1–12. [Google Scholar]
- Kunova, A.; Bonaldi, M.; Saracchi, M.; Pizzatti, C.; Chen, X.; Cortesi, P. Selection of Streptomyces against soil borne fungal pathogens by a standardized dual culture assay and evaluation of their effects on seed germination and plant growth. BMC Microbiol. 2016, 16, 272. [Google Scholar] [CrossRef]
- Bercovich, B.A.; Villafañe, D.L.; Bianchi, J.S.; Taddia, C.; Gramajo, H.; Chiesa, M.A.; Rodríguez, E. Streptomyces eurocidicus promotes soybean growth and protects it from fungal infections. Biol. Control 2022, 165, 104821. [Google Scholar] [CrossRef]
- Shahidi-Bonjar, G.H.; Aghighi, S. Chitinolytic and microsclerostatic activity of Iranian strains of Streptomyces plicatus and Frankia sp. on olive isolate of Verticillium dahliae. Biotechnology 2005, 4, 108–113. [Google Scholar]
- Bubici, G.; Marsico, A.D.; D’Amico, M.; Amenduni, M.; Cirulli, M. Evaluation of Streptomyces spp. for the biological control of corky root of tomato and Verticillium wilt of eggplant. Appl. Soil Ecol. 2013, 72, 128–134. [Google Scholar] [CrossRef]
- Xue, L.; Xue, Q.; Chen, Q.; Lin, C.; Shen, G.; Zhao, J. Isolation and evaluation of rhizosphere actinomycetes with potential application for biocontrol of Verticillium wilt of cotton. Crop Prot. 2013, 43, 231–240. [Google Scholar] [CrossRef]
- Calvo-Peña, C.; Cobos, R.; Sánchez-López, J.M.; Ibañez, A.; Coque, J.J.R. Albocycline is the main bioactive antifungal compound produced by Streptomyces sp. OR6 against Verticillium dahliae. Plants 2023, 12, 3612. [Google Scholar] [CrossRef] [PubMed]
- Errakhi, R.; Lebrihi, A.; Barakate, M. In vitro and in vivo antagonism of actinomycetes isolated from Moroccan rhizospherical soils against Sclerotium rolfsii: A causal agent of root rot on sugar beet (Beta vulgaris L.). J. Appl. Microbiol. 2009, 107, 672–681. [Google Scholar] [CrossRef] [PubMed]
- Yang, Y.; Zhang, S.W.; Zhang, Y.; Liu, Q.; Li, K.T. Antifungal activities and stability of fermentation broth from Streptomyces corchorusii strain AUH-1. Biotechnol. Bull. 2019, 35, 80. [Google Scholar]
- Carlucci, A.; Raimondo, M.L.; Colucci, D.; Lops, F. Streptomyces albidoflavus Strain CARA17 as a biocontrol agent against fungal soil-borne pathogens of fennel plants. Plants 2022, 11, 1420. [Google Scholar] [CrossRef]
- López-Moral, A.; Agustí-Brisach, C.; Ruiz-Blancas, C.; Antón-Domínguez, B.I.; Alcántara, E.; Trapero, A. Elucidating the effect of nutritional imbalances of N and K on the infection of Verticillium dahliae in olive. J. Fungi 2022, 8, 139. [Google Scholar] [CrossRef]
- Blanco-López, M.A.; Bejarano-Alcázar, J.; Malero-Vera, J.M.; Jiménez-Díaz, R.M. Current status of Verticillium wilt of cotton in southern Spain: Pathogen variation and population in soil. In Vascular Wilt Diseases of Plants; Tjamos, E.C., Beckman, C.H., Eds.; Springer: Berlin/Heidelberg, Germany, 1989; pp. 123–132. [Google Scholar]
- Díaz-Díaz, M.; Bernal-Cabrera, A.; Trapero, A.; Medina-Marrero, R.; Sifontes-Rodríguez, S.; Cupull-Santana, R.D.; Agustí-Brisach, C. Characterization of actinobacterial strains as potential biocontrol agents against Macrophomina phaseolina and Rhizoctonia solani, the main soil-Borne pathogens of Phaseolus vulgaris in Cuba. Plants 2022, 11, 645. [Google Scholar] [CrossRef]
- Lane, D.J.; Pace, B.; Olsen, G.J.; Stahl, D.A.; Sogin, M.L.; Pace, N.R. Rapid determination of 16S ribosomal RNA sequences for phylogenetic analysis. Proc. Natl. Acad. Sci. USA 1985, 82, 6955–6959. [Google Scholar] [CrossRef] [PubMed]
- Lane, D.J. 16S/23S rRNA Sequencing. In Nucleic Acid Techniques in Bacterial Systematics; Stackebrandt, E., Goodfellow, M., Eds.; John Wiley and Sons: Chichester, UK, 1991; pp. 115–175. [Google Scholar]
- Jiang, H.; Dong, H.; Zhang, G.; Yu, B.; Chapman, L.R.; Fields, M.W. Microbial diversity in water and sediment of Lake Chaka, an athalassohaline lake in northwestern China. Appl. Environ. Microbiol. 2006, 72, 3832–3845. [Google Scholar] [CrossRef] [PubMed]
- Pernodet, J.L.; Alegre, M.T.; Boccard, F.; Guerinea, M. Organization and nucleotide sequence of a ribosomal RNA gene cluster from Streptomyces ambofaciens. Gene 1989, 79, 33–46. [Google Scholar] [CrossRef] [PubMed]
- Stackebrandt, E.; Witt, D.; Kemmerling, C.; Kroppenstedt, R.; Liesack, W. Designation of Streptomycete 16S and 23S rRNA-based target regions for oligonucleotide probes. Appl. Environ. Microbiol. 1991, 57, 1468–1477. [Google Scholar] [CrossRef] [PubMed]
- Tamura, K.; Stecher, G.; Kumar, S. MEGA11: Molecular evolutionary genetics analysis version 11. Mol. Biol. Evol. 2021, 38, 3022–3027. [Google Scholar] [CrossRef] [PubMed]
- Felsenstein, J. Confidence limits on phylogenies: An approach using the bootstrap. Evolution 1985, 39, 783–791. [Google Scholar] [CrossRef] [PubMed]
- Trapero, C.; Serrano, N.; Arquero, O.; Del Río, C.; Trapero, A.; López-Escudero, F.J. Field resistance to Verticillium wilt in selected olive cultivars grown in two naturally infested soils. Plant Dis. 2013, 97, 668–674. [Google Scholar] [CrossRef] [PubMed]
- Huisman, O.C.; Ashworth, L.J., Jr. Quantitative assessment of Verticillium alboatrum in field soils: Procedural and substrate improvements. Phytopathology 1974, 64, 1043–1044. [Google Scholar] [CrossRef]
- Butterfield, E.J.; DeVay, J.E. Reassessment of soil assays for Verticillium dahliae. Phytopathology 1977, 67, 1073–1078. [Google Scholar] [CrossRef]
- López-Escudero, F.J.; Del-Río, C.; Caballero, J.M.; Blanco-López, M.A. Evaluation of olive cultivars for resistance to Verticillium dahliae. Eur. J. Plant Pathol. 2004, 110, 79–85. [Google Scholar] [CrossRef]
- Campbell, C.L.; Madden, L.V. Introduction to Plant Disease Epidemiology; John Wiley & Sons Ltd.: New York, NY, USA, 1990. [Google Scholar]
- Steel, R.G.D.; Torrie, J.H. Bioestadística, 2nd ed.; McGraw-Hill: Bogotá, Colombia, 1985. [Google Scholar]
- Zar, J.H. Biostatistical Analysis, 5th ed.; Pte Pearson Education: Singapore, 2010. [Google Scholar]
- Analytical SoftwareStatistix, version 10; User’s Manual; Statistix: Tallahassee, FL, USA, 2013.
- Díaz-Díaz, M.; Bernal-Cabrera, A.; Trapero, A.; Jiménez-González, A.; Medina-Marrero, R.; Cupull-Santana, R.D.; Águila-Jiménez, E.; Agustí-Brisach, C. Biocontrol of root rot complex disease of Phaseolus vulgaris by Streptomyces sp. strains in the field. Crop Prot. 2023, 165, 106164. [Google Scholar] [CrossRef]
- Cumsille, A.; Undabarrena, A.; González, V.; Claverías, F.; Rojas, C.; Cámara, B. Biodiversity of actinobacteria from the South Pacific and the assessment of Streptomyces chemical diversity with metabolic profiling. Mar. Drugs 2017, 15, 286. [Google Scholar] [CrossRef] [PubMed]
- Chen, Y.; Zhang, Q.; Feng, X.; Wojnowska, M.; O’Hagan, D. Streptomyces aureorectus DSM 41692 and Streptomyces virens DSM 41465 are producers of the antibiotic nucleocidin and 4′-fluoroadenosine is identified as a co-product. Org. Biomol. Chem. 2021, 19, 10081–10084. [Google Scholar] [CrossRef] [PubMed]
- Ayed, A.; Essid, R.; Jallouli, S.; Ben Zaied, A.; Ben Fdhila, S.; Limam, F.; Tabbene, O. Antifungal activity of volatile organic compounds (VOCs) produced by Streptomyces olivochromogenes S103 against Candida albicans. Euro-Mediterr. J. Environ. Integr. 2022, 7, 251–255. [Google Scholar] [CrossRef]
- Khadayat, K.; Sherpa, D.D.; Malla, K.P.; Shrestha, S.; Rana, N.; Marasini, B.P.; Parajuli, N. Molecular identification and antimicrobial potential of Streptomyces species from Nepalese soil. Int. J. Microbiol. 2020, 2020, 8817467. [Google Scholar] [CrossRef] [PubMed]
- Chen, Q.; Bai, S.; Zhang, T.; Duan, C.; Zhao, J.; Xue, Q.; Li, Y. Effects of seed-coating preparations of living Streptomyces globisporus on plant growth promotion and disease control against Verticillium wilt in cotton. Sustainability 2021, 13, 6001. [Google Scholar] [CrossRef]
- Xue, L.; Wang, J.; Liu, X.; Xue, Q.; Shen, G.; Zhao, J. Inhibition of antagonistic Streptomyces spp. on microsclerotia formation and germination of Verticillium dahliae. Acta Phytophylacica Sin. 2012, 39, 289–296. [Google Scholar]
- Aghighi, S.; Shahidi-Bonjar, G.H.; Saadoun, I. First report of antifungal properties of a new strain of Streptomyces plicatus (strain101) against four Iranian phytopathogenic isolates of Verticillium dahliae, a new horizon in biocontrol agents. Biotechnology 2004, 3, 90–97. [Google Scholar]
- Meschke, H.; Schrempf, H. Streptomyces lividans inhibits the proliferation of the fungus Verticillium dahliae on seeds and roots of Arabidopsis thaliana. Microb. Biotechnol. 2010, 3, 428–443. [Google Scholar] [CrossRef]

| Streptomyces Species | Strain | Host | Origin | Collection Date | GenBank Acc. Number | |
|---|---|---|---|---|---|---|
| 16S rRNA | 23S rRNA | |||||
| Streptomyces albidoflavus | UST040711-291 | - * | - | 2009 | FJ591130 | - |
| CCOS 2040 | Grasslands soil | Switzerland | 2009 | - | OX371414 | |
| SM254 | Deep subsurface | USA | 2010 | - | CP014485 | |
| RSU1 | Mangrove soil | India | 2012 | KP698738 | ||
| IHBA_9992 | Suraj Tal Lake Water | 2015 | KR085950 | - | ||
| TN10 | Termite nest | India | 2017 | MH021968 | - | |
| IMB16-111 | Marine sediment | China | 2017 | MG190667 | - | |
| UYFA156 | Seed Festuca arundinacea | Uruguay | 2014 | - | CP040466 | |
| NBRC 13010 | - | - | - | NR041095 | - | |
| J1074 | - | - | - | - | DS999645 | |
| S. albogriseolu | LBX-2 | Soil | China | 2012 | - | CP042594 |
| S. aquilus | GGCR-6 | Xanthium sibiricum | China | 2017 | - | CP034463 |
| S. argenteolus | CGMCC 4.1693 | - | - | - | EU048540 | - |
| S. aurantiacus | JCM 4677 | - | - | - | - | AP023440 |
| S. aureoverticillatus | HN6 | Soil | China | 2015 | - | CP048641 |
| S. avermitilis | MA-4680 | - | - | - | - | NR076331 |
| S. calvus | DSM 41452 | - | - | - | - | CP022310 |
| S. caviscabies | 8 | Solanum tuberosum | - | 2016 | KU743151 | - |
| S. champavatii | 173855 | - | - | 2008 | EU570590 | - |
| S. coeruleorubidus | ATCC 13740 | Soil | - | - | - | CP023694 |
| S. cyanogenus | S136 | Soil/Goa mountain | India | 1985 | - | CP071839 |
| S. daghestanicus | ICN1054 | Marine | India | 2010 | KX775313 | - |
| S. deccanensis | KCTC 19241 | - | China | 2019 | - | CP092431 |
| S. dengpaensis | XZHG99 | Soil | China | - | - | CP026654 |
| S. exfoliatus | 3-11 | Yalu River | North Korea | 2014 | KJ571038 | - |
| USC006 | Fresh water | Australia | - | KX358629 | - | |
| S. fodineus | TW1S1 | Soil | South Korea | 2015 | - | CP017248 |
| S. griseus | NBRC 13350 | Soil | - | - | - | NC010572 |
| MS098 | - | - | 2009 | GU169072 | - | |
| S. hydrogenans | IMB16-184 | Marine sediment | China | 2017 | MG190777 | - |
| IMB16-142 | Marine sediment | China | 2017 | MG190741 | - | |
| S. koyangensi | VK-A60T | Soil | South Korea | 2005 | - | CP031742 |
| SCSIO 5802 | Deep sea sediment | China | 2016 | - | CP049945 | |
| B003 | Sediment | - | 2019 | MG188671 | - | |
| S. krainskii | RSU51 | Mangrove soil | India | 2012 | KP698745 | - |
| S. lividans | RSU26 | Mangrove soil | India | 2012 | KP698743 | - |
| XQ42 | Euphausia superba | China | 2012 | KU291358 | - | |
| T38 | Soil | China | 2016 | KU317912 | - | |
| S. nodosus | ATCC 14899 | Soil | - | - | - | CP023747 |
| S. phaeoluteigriseus | Qhu-M197 | Soil | China | 2019 | - | CP099468 |
| S. rutgersensis | NBH77 | Soil | Antarctica | 2017 | - | CP045705 |
| S. violascens | KLBMP 5501 | Ginkgo biloba L. | - | 2015 | KP636799 | - |
| IMB16-161 | Marine sediment | China | 2017 | MG190757 | - | |
| IMB16-135 | Marine sediment | China | 2017 | MG190734 | - | |
| ATCC 27968 | Marine soil | China | 2017 | - | CP029377 | |
| EGI125 | - | - | 2019 | MN704434 | - | |
| S. scabiei | 87.79 | - | - | - | - | AB041112 |
| S. sampsonii | KJ40 | Soil | South Korea | 2005 | CP016824 | |
| GACK10 | Soil | - | 2015 | KP970678 | - | |
| S. seoulensis | HEK131 | Soil | Japan | 2014 | - | AP025667 |
| S. somaliensis | IMB16-131 | Marine sediment | China | 2017 | MG190730 | - |
| Streptomyces spp. | CBQ-B-8 | Rhizosphere, Carbonated brown | Cuba | 2008 | OM417234 | OR246887 |
| CBQ-CB-14 | Sediment | Cuba | 2013 | OR251853 | OR246888 | |
| CBQ-CD-24 | Rhizosphere | Cuba | 2014 | OR251854 | OR246889 | |
| CBQ-EA-2 | Endophytic, stem of Mosiera bullata | Cuba | 2008 | OM417233 | OR246890 | |
| CBQ-EA-12 | Endophytic, leaf of Mosiera bullata | Cuba | 2011 | OR251856 | OR246891 | |
| CBQ-EBa-21 | Endophytic, root of Piper aducum | Cuba | 2011 | OR251857 | OR246892 | |
| IMB16-161 | Marine sediment | China | 2017 | MG190757 | - | |
| IMB16-135 | Marine sediment | China | 2017 | MG190734 | - | |
| ATCC 27968 | Marine soil | China | 2017 | - | CP029377 | |
| S. sudanensis | MRC006 | Mycetoma patient | Sudan | 2016 | JAJQLO000000000 | |
| BCA Species | BCA Strain | MGI (%) a |
|---|---|---|
| Streptomyces spp. | CBQ-B-8 | 42.8 ± 1.50 c |
| CBQ-CB-14 | 42.3 ± 1.05 c | |
| CBQ-CD-24 | 37.3 ± 1.31 cd | |
| CBQ-EA-2 | 44.4 ± 1.67 c | |
| CBQ-EA-12 | 33.6 ± 2.91 d | |
| CBQ-EBa-21 | 39.0 ± 2.89 cd | |
| Aureobasidium pullulans | AP08 | 52.1 ± 1.83 b |
| Fusarium oxysporum | FO12 | 76.4 ± 1.87 a |
| Treatment (BCAs) | Isolate | Incidence (%) b,e | Mortality (%) b,e | Final DS c,f | RAUDPC (%) d,f |
|---|---|---|---|---|---|
| Streptomyces spp. | CBQ-B-8 | 80.0 bc | 13.3 abc | 1.2 ± 0.49 bc | 55.1 ± 22.9 ab |
| CBQ-CB-14 | 60.0 cd | 6.7 c | 0.6 ± 0.19 cd | 18.8 ± 6.6 bc | |
| CBQ-CD-24 | 73.3 cd | 0.0 d | 1.1 ± 0.18 cd | 34.7 ± 2.2 bc | |
| CBQ-EA-2 | 66.7 cd | 0.0 d | 0.9 ± 0.10 cd | 22.9 ± 2.5 bc | |
| CBQ-EA-12 | 80.0 bc | 6.7 c | 0.9 ± 0.41 cd | 27.5 ± 11.7 bc | |
| CBQ-EBa-21 | 60.0 cd | 6.7 c | 0.2 ± 0.03 d | 4.0 ± 0.94 c | |
| CBQ-EA-2 + CBQ-B-8 | 73.3 cd | 6.7 c | 1.0 ± 0.12 cd | 30.7 ± 1.0 bc | |
| Aureobasidium pullulans | AP08 | 100 a | 26.7 a | 2.2 ± 0.39 a | 92.8 ± 12.1 a |
| Fusarium oxysporum | FO12 | 66.7 cd | 0.0 d | 0.3 ± 0.13 d | 15.7 ± 9.9 bc |
| Negative control | - | 0.0 e | 0.0 d | 0.0 ± 0.0 e | 0.0 ± 0.0 d |
| Positive control | - | 93.3 ab | 20.0 a | 2.0 ± 0.41 ab | 100 ± 39.5 a |
Disclaimer/Publisher’s Note: The statements, opinions and data contained in all publications are solely those of the individual author(s) and contributor(s) and not of MDPI and/or the editor(s). MDPI and/or the editor(s) disclaim responsibility for any injury to people or property resulting from any ideas, methods, instructions or products referred to in the content. |
© 2024 by the authors. Licensee MDPI, Basel, Switzerland. This article is an open access article distributed under the terms and conditions of the Creative Commons Attribution (CC BY) license (https://creativecommons.org/licenses/by/4.0/).
Share and Cite
Díaz-Díaz, M.; Antón-Domínguez, B.I.; Raya, M.C.; Bernal-Cabrera, A.; Medina-Marrero, R.; Trapero, A.; Agustí-Brisach, C. Streptomyces spp. Strains as Potential Biological Control Agents against Verticillium Wilt of Olive. J. Fungi 2024, 10, 138. https://doi.org/10.3390/jof10020138
Díaz-Díaz M, Antón-Domínguez BI, Raya MC, Bernal-Cabrera A, Medina-Marrero R, Trapero A, Agustí-Brisach C. Streptomyces spp. Strains as Potential Biological Control Agents against Verticillium Wilt of Olive. Journal of Fungi. 2024; 10(2):138. https://doi.org/10.3390/jof10020138
Chicago/Turabian StyleDíaz-Díaz, Miriam, Begoña I. Antón-Domínguez, María Carmen Raya, Alexander Bernal-Cabrera, Ricardo Medina-Marrero, Antonio Trapero, and Carlos Agustí-Brisach. 2024. "Streptomyces spp. Strains as Potential Biological Control Agents against Verticillium Wilt of Olive" Journal of Fungi 10, no. 2: 138. https://doi.org/10.3390/jof10020138
APA StyleDíaz-Díaz, M., Antón-Domínguez, B. I., Raya, M. C., Bernal-Cabrera, A., Medina-Marrero, R., Trapero, A., & Agustí-Brisach, C. (2024). Streptomyces spp. Strains as Potential Biological Control Agents against Verticillium Wilt of Olive. Journal of Fungi, 10(2), 138. https://doi.org/10.3390/jof10020138

